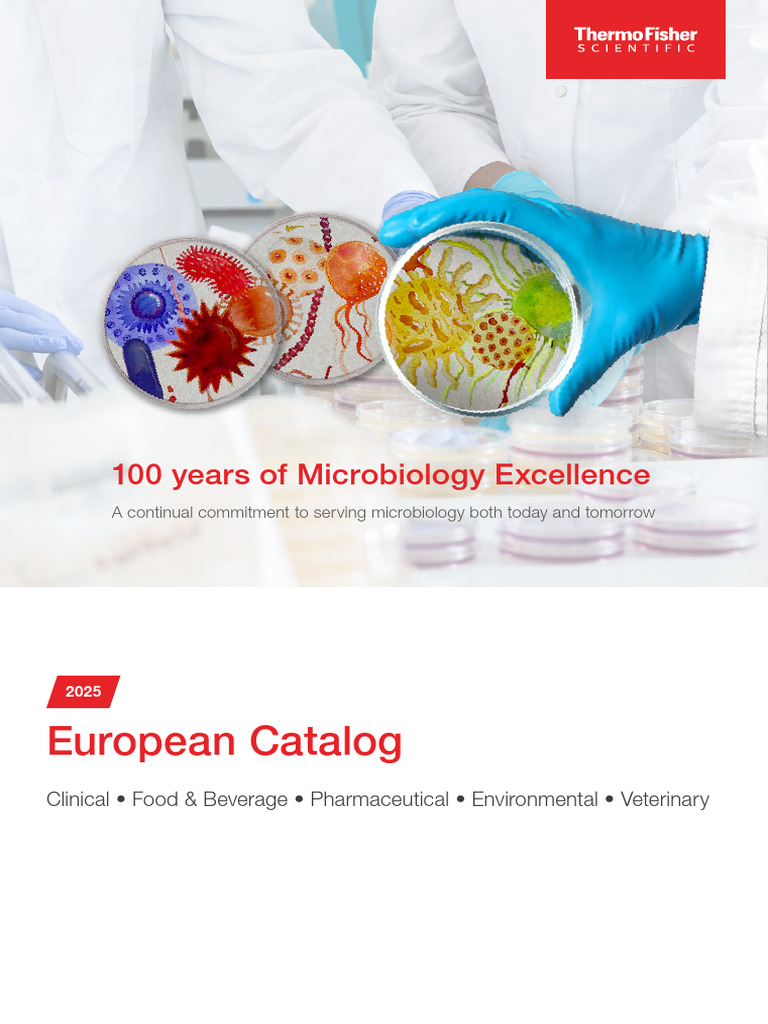

Microbiology Catalog
Microbiology Catalog - The Professional's Chart: Achieving Academic and Career GoalsIn the structured, goal-oriented environments of the workplace and academia, the printable chart proves to be an essential tool for creating clarity, managing complexity, and driving success. Always start with the simplest, most likely cause and work your way up to more complex possibilities. Patterns also offer a sense of predictability and familiarity. A print catalog is a static, finite, and immutable object. Where a modernist building might be a severe glass and steel box, a postmodernist one might incorporate classical columns in bright pink plastic. The rise of template-driven platforms, most notably Canva, has fundamentally changed the landscape of visual communication. Time Efficiency: Templates eliminate the need to start from scratch, allowing users to quickly produce professional-quality documents, designs, or websites. Over-reliance on AI without a critical human eye could lead to the proliferation of meaningless or even biased visualizations. Flipping through its pages is like walking through the hallways of a half-forgotten dream. Let us now turn our attention to a different kind of sample, a much older and more austere artifact. The rise of artificial intelligence is also changing the landscape. 64 This deliberate friction inherent in an analog chart is precisely what makes it such an effective tool for personal productivity. This could be incredibly valuable for accessibility, or for monitoring complex, real-time data streams. Any good physical template is a guide for the hand. These digital patterns can be printed or used in digital layouts. The second and third-row seats can be folded flat to create a vast, continuous cargo area for transporting larger items. It was produced by a team working within a strict set of rules, a shared mental template for how a page should be constructed—the size of the illustrations, the style of the typography, the way the price was always presented. The goal is not just to sell a product, but to sell a sense of belonging to a certain tribe, a certain aesthetic sensibility. You still have to do the work of actually generating the ideas, and I've learned that this is not a passive waiting game but an active, structured process. Indigenous art, for instance, often incorporates patterns that hold cultural and spiritual significance. The journey of the catalog, from a handwritten list on a clay tablet to a personalized, AI-driven, augmented reality experience, is a story about a fundamental human impulse. What are the materials? How are the legs joined to the seat? What does the curve of the backrest say about its intended user? Is it designed for long, leisurely sitting, or for a quick, temporary rest? It’s looking at a ticket stub and analyzing the information hierarchy. The journey of the catalog, from a handwritten list on a clay tablet to a personalized, AI-driven, augmented reality experience, is a story about a fundamental human impulse. This includes the cost of research and development, the salaries of the engineers who designed the product's function, the fees paid to the designers who shaped its form, and the immense investment in branding and marketing that gives the object a place in our cultural consciousness. One of the most frustrating but necessary parts of the idea generation process is learning to trust in the power of incubation. Journaling allows for the documentation of both successes and setbacks, providing valuable insights into what strategies work best and where improvements are needed. A flowchart visually maps the sequential steps of a process, using standardized symbols to represent actions, decisions, inputs, and outputs. This is the magic of a good template. It’s not just seeing a chair; it’s asking why it was made that way. That figure is not an arbitrary invention; it is itself a complex story, an economic artifact that represents the culmination of a long and intricate chain of activities. Every search query, every click, every abandoned cart was a piece of data, a breadcrumb of desire. Over-reliance on AI without a critical human eye could lead to the proliferation of meaningless or even biased visualizations. The sheer variety of items available as free printables is a testament to the creativity of their makers and the breadth of human needs they address. In addition to its artistic value, drawing also has practical applications in various fields, including design, architecture, engineering, and education. They were the holy trinity of Microsoft Excel, the dreary, unavoidable illustrations in my high school science textbooks, and the butt of jokes in business presentations. A 3D printer reads this specialized printable file and constructs the object layer by layer from materials such as plastic, resin, or even metal. It’s about using your creative skills to achieve an external objective. I had been trying to create something from nothing, expecting my mind to be a generator when it's actually a synthesizer. 30 For educators, the printable chart is a cornerstone of the learning environment. There is an ethical dimension to our work that we have a responsibility to consider. 41 It also serves as a critical tool for strategic initiatives like succession planning and talent management, providing a clear overview of the hierarchy and potential career paths within the organization. The very idea of a printable has become far more ambitious. There are even specialized charts like a babysitter information chart, which provides a single, organized sheet with all the essential contact numbers and instructions needed in an emergency. It uses evocative, sensory language to describe the flavor and texture of the fruit. The Lane Keeping Assist system helps prevent unintentional lane departures by providing gentle steering inputs to keep the vehicle centered in its lane. The copy is intellectual, spare, and confident. You can also zoom in on diagrams and illustrations to see intricate details with perfect clarity, which is especially helpful for understanding complex assembly instructions or identifying small parts. " This principle, supported by Allan Paivio's dual-coding theory, posits that our brains process and store visual and verbal information in separate but related systems. I read the classic 1954 book "How to Lie with Statistics" by Darrell Huff, and it felt like being given a decoder ring for a secret, deceptive language I had been seeing my whole life without understanding. It transforms the consumer from a passive recipient of goods into a potential producer, capable of bringing a digital design to life in their own home or workshop. There is the cost of the factory itself, the land it sits on, the maintenance of its equipment. You should also check the engine coolant level in the reservoir located in the engine bay; it should be between the 'MIN' and 'MAX' lines when the engine is cool. It is printed in a bold, clear typeface, a statement of fact in a sea of persuasive adjectives. The invention of desktop publishing software in the 1980s, with programs like PageMaker, made this concept more explicit. Before beginning any journey, it is good practice to perform a few simple checks to ensure your vehicle is ready for the road. But it is never a direct perception; it is always a constructed one, a carefully curated representation whose effectiveness and honesty depend entirely on the skill and integrity of its creator. The image should be proofed and tested by printing a draft version to check for any issues. Users can simply select a template, customize it with their own data, and use drag-and-drop functionality to adjust colors, fonts, and other design elements to fit their specific needs. It is a primary engine of idea generation at the very beginning. An invoice template in a spreadsheet application is an essential tool for freelancers and small businesses, providing a ready-made, professional document for billing clients. He likes gardening, history, and jazz. The page is stark, minimalist, and ordered by an uncompromising underlying grid. It is an act of respect for the brand, protecting its value and integrity. I had to research their histories, their personalities, and their technical performance. It's an argument, a story, a revelation, and a powerful tool for seeing the world in a new way. Beyond a simple study schedule, a comprehensive printable student planner chart can act as a command center for a student's entire life. 3 A printable chart directly capitalizes on this biological predisposition by converting dense data, abstract goals, or lengthy task lists into a format that the brain can rapidly comprehend and retain. The furniture is no longer presented in isolation as sculptural objects. His idea of the "data-ink ratio" was a revelation. This represents a radical democratization of design. With the caliper out of the way, you can now remove the old brake pads. It forces deliberation, encourages prioritization, and provides a tangible record of our journey that we can see, touch, and reflect upon. The printable economy is a testament to digital innovation. This catalog sample is a masterclass in functional, trust-building design. We see it in the monumental effort of the librarians at the ancient Library of Alexandria, who, under the guidance of Callimachus, created the *Pinakes*, a 120-volume catalog that listed and categorized the hundreds of thousands of scrolls in their collection. Some common types include: Reflect on Your Progress: Periodically review your work to see how far you've come. Challenge yourself to step out of your comfort zone and try something different. Market research is essential to understand what customers want. It uses evocative, sensory language to describe the flavor and texture of the fruit. Adjust the seat so that you can comfortably operate the accelerator and brake pedals with a slight bend in your knees, ensuring you do not have to stretch to reach them.Product catalogs Chromagar
Water Microbiology Product Catalog PDF Water Chemistry
Essentials of Microbiology for Postgraduates 1st/2025 (Vol 2) Best
Brochures of microbiology products and services
(PDF) KxGew1Pharmaceutical Microbiology Catalog · A Culture of Service
Catalog A4 Microbiology and Viruses. 3d Microscopic Stock Vector
Brochures of microbiology products and services
Microbiology Product Catalog 2020 2021 PDF Laboratory Techniques
VBD Publications
Brochures of microbiology products and services
Promo Microbiology An Introduction 11th Edition International
2025 EU Microbiology Catalog EN PDF Beta Lactamase Antibiotics
Brochures of microbiology products and services
Brochures of microbiology products and services
StatLab Microbiology
TMS Microbiology Catalogue Team Medical & Scientific Sdn Bhd
Brochures of microbiology products and services
Brochures of microbiology products and services
A&P and Microbiology 2025 Asia Catalog by McGraw Hill International
Compact Dry Catalog 2022 PDF Filtration Microbiology
Catalog A4 Microbiology and Viruses. 3d Microscopic Stock Vector
Calaméo Catalogue VWR For Microbiology FR 171116
Catalog A4 Microbiology and Viruses. 3d Microscopic Stock Vector
(PDF) 2017 Immunology and Microbiology Catalog DOKUMEN.TIPS
Microbiology Product Catalog EU en PDF Elisa Antibiotics
Visualizing Microbiology, 2nd Edition WileyPLUS
Brochures of microbiology products and services
Catalog A4 Microbiology and Viruses. 3d Microscopic Stock Vector
GSC Equipment Catalog 2019 Microbiology Laboratory PDF Molecular
Brochures of microbiology products and services
Brochures of microbiology products and services
Laboratory Products Microbiology Catalog
EcoliDx Product Catalog 2021 Download Free PDF Sexually Transmitted
Microbiology Lab Solutions Macmillan Learning US
Brochures of microbiology products and services
Related Post: